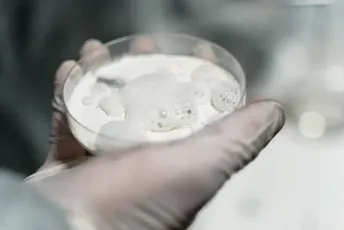
Bern: Parlament izglasao slobodnu prodaju kokaina Bern: Parlament izglasao slobodnu prodaju kokaina

Mnogi ovo tumače kao pokušaj da Švajcarci traže zamjenu za globalni status bankarske nacije nakon propasti Kredit Svis banke, dok drugi smatraju kako se radi samo o tome da se uspostavi kontrola na narko tržištu, prenose lokalni mediji.
Međutim, da bi prodaja kokaina bila legalizovana, zakon bi trebalo da usvoji vlada na saveznom nivou.
Švajcarska narodna partija, FDP. Liberali i Evangelistička partija, zajedno sa nekim članovima Socijaldemokratske partije, glasali su protiv predloga.
Protivnici su tvrdili da tako ozbiljno pitanje kao što je nadgledana prodaja kokaina treba u potpunosti prepustiti saveznoj vladi, a ne gradu.
Prvi put je slobodna prodaja kokaina predložena u Bernu 2019. godine, ali je tada ipak bila odbijena.